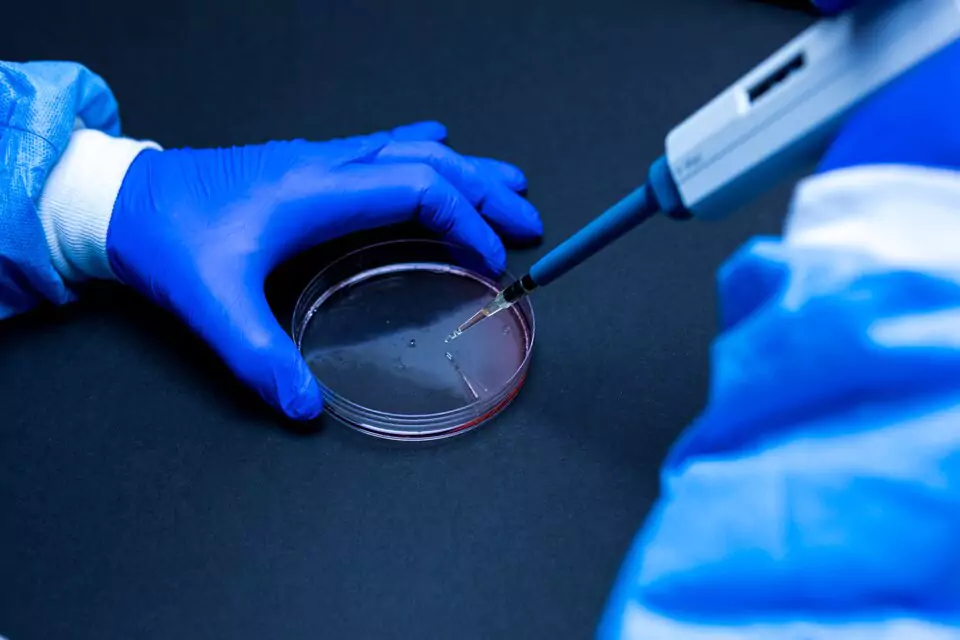
surgical sperm retrieval

Surgical Sperm Retrieval Procedure in Kompally, Hyderabad
Surgical Sperm retrieval is a delicate technology with the male fertility clinic Pozitiv, that aims at extraction of the sperms directly out of male reproductive system. It helps especially in patients with azoospermia in which there is a lack of sperm in semen because of either obstruction or non-obstruction. This surgical retrieval process of sperms in Kompally, Hyderabad offer good means of providing viable sperms used in IVF procedures since the natural ejaculation cannot take place.






Each specialist at Pozitiv brings not just exceptional medical expertise but a personal dedication to your journey. They are your partners in hope, your guides through uncertainty, and your champions in the face of challenges.

Surgeon & Andrologist View Profile

Reproductive Medicine and Gynaecology View Profile
Fertility-Related Indications:
Diagnostic Indications:
Pozitiv specialises in state of the art surgery-based sperm recovery. We offer the best solutions to male infertility using a team of fertility experts. Are you wanting to make an appointment with a surgical sperm treatment or finding the most effective IVF centre? Pozitiv provides professional treatment with personal service in order to have good results.
Climb the first step of making a family by arranging a consultation on our surgical sperm retrieval procedure afforded by IVF clinic in Pozitiv, Kompally, Hyderabad and get good advice and a helping hand of our decorated fertility specialists in Hyderabad.
Yes, surgical sperm retrieval is highly successful, especially when performed by experienced specialists. Success depends on the underlying cause of infertility and the technique used.
Most men experience mild discomfort, swelling, or bruising. Serious complications are rare but may include infection or bleeding, which are manageable with medical care.
Recovery is usually quick. Most men can return to normal activities within 1–2 days, though strenuous activity should be avoided for about a week.

At Pozitiv, we turn your dream of parenthood into reality with personalised fertility care – bringing joy, hope, and new beginnings.